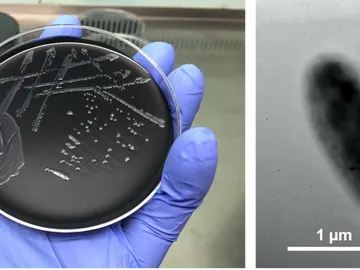

Astronomía, divulgación, descubrimientos, ecología, innovación...

Descubierto un hongo con actividad antibacteriana al sur de Ecuador
Descubierta una nueva especie de legionella en Mallorca

¿Es cierto que los gérmenes se transmiten más dando la mano que besando?

Qué es el estreptococo A y cómo se contagia

Francia investiga un brote de 'E. coli' que causó la muerte a un niño
